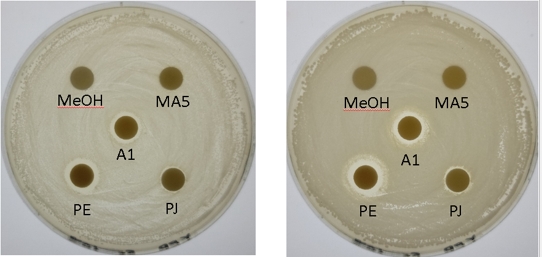

The use of probiotics as alternatives to traditional medications has become a key strategy in shrimp farming management.
As environmental sustainability and eco-friendly practices gain increasing attention in the modern consumer market, the use of probiotics and natural additives as alternatives to traditional medications has become a key strategy in shrimp farming management.
Concept of Using Probiotics
Probiotics refer to beneficial live microorganisms that, when added in appropriate amounts to feed or water, can regulate intestinal microflora, inhibit pathogenic bacteria growth, and enhance the overall health of shrimp. Common probiotics used in shrimp farming include Lactobacillus, Bacillus, Saccharomyces (yeast), and Clostridium butyricum. Depending on the application method, probiotics can be classified into two types:
- Feed-additive probiotics: These probiotics are incorporated directly into shrimp feed, where they exert effects through ingestion. They promote gut health, enhance digestive enzyme activity, and strengthen immune function.
- Water-conditioning probiotics: These probiotics are applied directly to the aquaculture pond to suppress harmful bacteria, decompose organic waste, and improve water quality, ultimately reducing the occurrence of shrimp diseases.
Feed additives are one of the main ways to use probiotics in shrimp farming.
Mechanism of Probiotics
Probiotics play several critical roles in shrimp farming, including:
1. Regulating Gut Microbiota and Enhancing Digestion & Absorption
The shrimp gut serves as a vital physiological barrier during farming, and the balance of gut microbiota directly affects digestion and growth. Probiotics can colonize the intestinal epithelium, competing with pathogens for nutrients and adhesion sites, preventing harmful bacterial overgrowth. Additionally, some probiotics produce digestive enzymes (e.g., protease, lipase, amylase), which improve feed digestibility, enhance FCR, and promote shrimp growth.
2. Producing Antimicrobial Peptides to Inhibit Pathogens
Certain probiotics, such as Bacillus species, produce antimicrobial peptides like Iturin and Surfactin within the shrimp body or environment. These compounds can directly inhibit the growth of multiple pathogens, including Vibrio species, reducing pathogen load and minimizing disease risks.
The inhibition zones on the culture medium indicate that the probiotics have the ability to inhibit pathogenic bacteria.
3. Stimulating the Immune System and Enhancing Disease Resistance
Beyond directly inhibiting pathogens, some probiotics enhance shrimp defense mechanisms by modulating nonspecific immune responses. For example, Lactobacillus can stimulate the production of Lysozyme and Catalase, improving resistance against bacterial and viral infections. Likewise, Bacillus species can induce the expression of immune-related genes, enhancing shrimp resistance to various pathogens.
4. Decomposing Organic Waste and Improving Water Quality
Organic waste accumulation in shrimp ponds (e.g., uneaten feed, feces) often leads to water quality deterioration and disease outbreaks. Certain probiotics, such as Bacillus species, can degrade organic matter, ammonia (NH₃-N), and nitrite (NO₂⁻), effectively reducing harmful substance concentrations and improving water conditions. Moreover, some nitrifying bacteria promote nitrification, decreasing toxic compounds' impact on shrimp and increasing survival rates.
By leveraging these mechanisms, probiotics provide a sustainable and effective approach to improving shrimp health, farm productivity, and overall profitability.
Author: Barry Cheng, Manager of Aquaculture Department